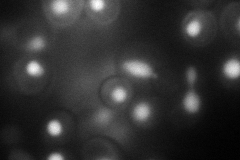

View description
RNA helicase in the DEAD-box family, involved in RNA isomerization at the 5' splice site
Localization:
Intensity:
Fold change:
Significance:
-
C’ GFP library in SD

nucleus25.71 -
N' NOP1pr-GFP in SD
nucleus74.0603 -
N' TEF2pr-mCherry in SD

nucleus105.684 -
N' NATIVEpr-GFP in SD

nucleus26.2414 -
N' TEF2pr-VC and Cyto-VN in SD

nucleus35.7424 -
C’ GFP library in SD+DTT

nucleus23.810.92No -
C’ GFP library in SD+H2O2

nucleus26.511.03No -
C’ GFP library in Starvation Media

nucleus21.160.82No -
C’ GFP library on the background of Pup2-DaMP

nucleus -
C’ GFP library on the background of CCT mutant

nucleus28.61311.11254No
